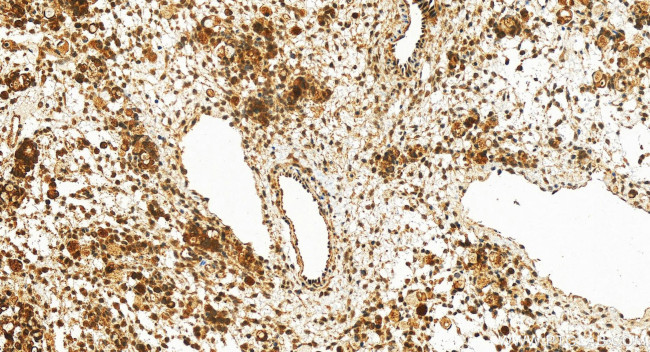
SIK2 Antibody in Immunohistochemistry (Paraffin) (IHC (P))

Search
Proteintech
SIK2 Polyclonal Antibody
{{$productOrderCtrl.translations['antibody.pdp.commerceCard.promotion.promotions']}}
{{$productOrderCtrl.translations['antibody.pdp.commerceCard.promotion.viewpromo']}}
{{$productOrderCtrl.translations['antibody.pdp.commerceCard.promotion.promocode']}}: {{promo.promoCode}} {{promo.promoTitle}} {{promo.promoDescription}}. {{$productOrderCtrl.translations['antibody.pdp.commerceCard.promotion.learnmore']}}
产品信息
27608-1-AP
种属反应
已发表种属
宿主/亚型
分类
类型
抗原
偶联物
形式
浓度
规格
纯化类型
保存液
内含物
保存条件
运输条件
产品详细信息
Immunogen sequence: VQLLYEQIGP EADPNLAPAA PQLQDLASSC PQEEVSQQQE SVSTLPASVH PQLSPRQSLE TQYLQHRLQK PSLLSKAQNT CQLYCKEPPR SLEQQLQEHR LQQKRLFLQK QSQLQAYFNQ MQIAESSYPQ PSQQLPLPRQ ETPPPSQQAP PFSLTQPLSP VLEPSSEQMQ YSPFLSQYQE MQLQPLPSTS GPRAAPPLPT QLQQQQPPPP PPPPPPRQPG AAPAPLQFSY QTCELPSAAS PAPDYPTPCQ YPVDGAQQSD LTGPDCPRSP GLQEAPSSYD PLALSELPGL FDCEMLDAVD PQHNGYVLVN
靶标信息
SNF1LK2 (QIK) is a serine/threonine kinase and is a salt-inducible kinase that belongs to the AMP-activated protein kinase family. SNF1LK2 negatively regulates CRE-binding protein (CREB) activity by phosphorylating the CREB-specific coactivator transducer of regulated CREB activity (TORC). SIK2 is thought to be part of a signaling cascade that regulates the expression and activity of the insulin-induced genes PGC-1'alpha and UCP-1 in brown adipocytes, impairment of which has been implicated in obesity and insulin resistance in human and animal models. SIK2 has also been reported as a key regulator for neuronal survival after ischemia, suppressing CREB-mediated gene expression after oxygen-glucose deprivation.
仅用于科研。不用于诊断过程。未经明确授权不得转售。
生物信息学
蛋白别名: Qin-induced kinase; Salt-inducible kinase 2; salt-inducible protein kinase 2; salt-inducible serine/threonine kinase 2; Serine/threonine-protein kinase SIK2; Serine/threonine-protein kinase SNF1-like kinase 2; SIK-2; SNF1-like kinase 2; unnamed protein product
基因别名: KIAA0781; LOH11CR1I; QIK; SIK-2; SIK2; SNF1LK2
UniProt ID: (Human) Q9H0K1
Entrez Gene ID: (Human) 23235